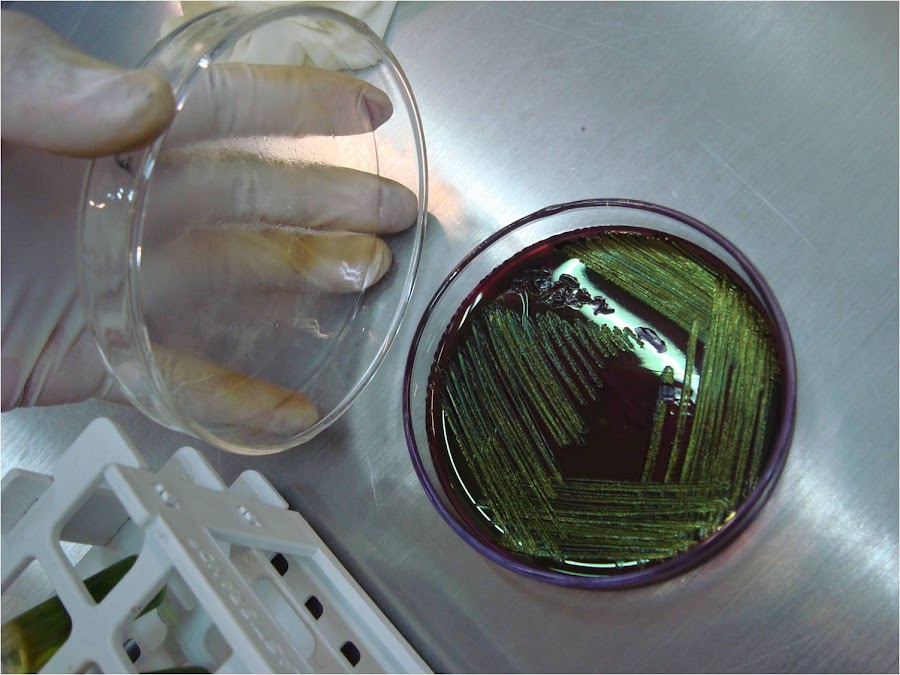

(Giacomo Leopardi)
GUÍA PRACTICA del LABORATORIO MICROBIOLOGICO (Parte 15)
ENTEROBACTERIAS y ESCHERICHIA COLI
Los alimentos para que se consideren de buena calidad higiénica deben estar exentos de microorganismos peligrosos, pero en general no es posible examinar los productos o alimentos para investigar la presencia de todos y cada uno de tales organismos. Esto se puede resolver determinando organismos indicadores, como coliformes y enterococos. Por lo que se refiere a los coliformes, la presencia de E. coli en un alimento indica generalmente una contaminación de origen fecal. Así E. coli es un indicador clásico de la presencia de patógenos entéricos en agua, moluscos, productos lácteos y otros alimentos. De la muestra madre a analizar, debidamente homogeneizada, se siembra en una placa de Petri estéril, 1 ml de ésa solución (siembra en profundidad), y luego se coloca una capa de Agar VRBG o VRBL a 45° C. Cuando solidifica se le coloca una segunda capa del mismo agar sobre la anterior (siembra en doble capa). Se incuba por 24 hs a 37° C y se cuentan las colonias de coliformes totales que serán rosadas por ser éste un medio específico para contaje de las mismas. Se aplicará el factor de dilución utilizado y el criterio microbiológico para cada alimento, según lo normatizado en el CAA. Para determinar la presencia de Escherichia coli, se sembrarán 10 ml del homogeneizado primario en 10 ml de Caldo BRILA, incubándose 48 hs a 44° C. Si hay formación de gas y viraje del color verde del medio al amarillo, se presume la presencia de E. coli, la cual debe confirmarse repicando en siembra por estrías y en superficie sobre una placa de Agar EMB de Levine que se incubará por 24 hs a 37° C (las colonias de E. coli son de 2 ‑ 3 mm de diámetro de color oscuro y con un brillo verde metálico muy característico en Levine). Asimismo se reconfirmarán las colonias, tipificándolas con las pruebas bioquímicas de rigor.
Las principales bacterias coliformes son Escherichia coli y Enterobacter aerogenes. La primera se encuentra normalmente en el tracto gastrointestinal del hombre y de los animales y raramente aparece en otro lugar, mientras que E. aerogenes se asocia normalmente con la vegetación y sólo ocasionalmente aparece en el intestino. En el análisis del agua E. coli es el indicador clásico de la posible presencia de patógenos entéricos. Hay una relación directa entre el número de E. coli e intensidad de la contaminación fecal, cuanto mayor es el número, mayor es la contaminación; esto es así porque los microorganismos no se multiplican en el agua y su número disminuye lentamente, a no ser que acaezca una nueva contaminación. En los alimentos la presencia y concentración de E. coli es de menor significado y su presencia, incluso en mayor número, no implica necesariamente una contaminación fecal intensa reciente. Su número está influenciado por muchos factores como crecimiento actual en el alimento, equipo deficientemente limpiado y contaminación a partir de las personas. Por lo tanto todo lo que puede concluirse con muchos alimentos es que la contaminación fecal, directa o indirecta, tuvo lugar en alguna fase de su obtención y que la seguridad sanitaria del alimento es cuestionable. La detección y enumeración de E. coli se lleva a cabo en tres fases. La primera, recuento presuntivo de coliformes, implica la enumeración de coliformes, tanto fecales como no fecales, en medios selectivos que pueden describirse brevemente como medios nutritivos que contienen agentes selectivos, como antibióticos, colorantes o productos químicos que suprimen el crecimiento de muchos microorganismos, pero permiten crecer a los organismos seleccionados, resistentes a los agentes citados. Del origen fecal de esta bacteria se concluye que su presencia en un alimento indica que éste ha tenido contacto con, y por tanto está contaminado por, materia de origen fecal. La supervivencia de estas bacterias en medios no entéricos es limitada por lo que su presencia indica una contaminación reciente. Por estas razones, E. coli es el microorganismo índice ideal para la detección de contaminaciones recientes.
La identificación del grupo coli – aerogenes se hace mediante la detección de microorganismos capaces de fermentar lactosa a 44º C en presencia de un 2% de bilis y de cristal violeta (Caldo BRILA). En alimentos tratados también conviene comprobar la presencia de coli – aerogenes mediante la producción de gas en verde brillante con 2% de lactosa, aunque esto no indica claramente contaminación fecal debido a los múltiples orígenes de las bacterias de este grupo. No es recomendable el uso del concepto de coliformes fecales definido por las que crecen en presencia de sales biliares a 44º C porque el grupo no está definido taxonómicamente y las diferencias experimentales en los procesos de detección son muy críticas. Las bacterias de este grupo pueden entrar en un proceso de autoesterilización debida a la producción de ácidos en sus procesos de fermentación, ácidos que terminan por matarlas. Por ello es necesario utilizar medios tamponados. En muchos casos es necesario hacer un tratamiento de recuperación de los microorganismos dañados en los procesos de preparación del alimento. E. coli es un buen índice mientras que las coliformes en general sólo son buenos índices si los números son inaceptablemente altos.
Esto es debido a que el origen de E. coli es únicamente intestinal, mientras que las coliformes pueden tener muchos otros orígenes. La detección de E. coli es muy importante en el análisis de aquellos alimentos compuestos en los que el tratamiento de cada una de las partes haya sido diferente. A partir de 1920, se introdujo la utilización del grupo total de las bacterias del grupo coli – aerogenes o coliformes como marcadores en análisis microbiológico de la leche pasteurizada y de los helados, basándose en el principio de que un tratamiento térmico adecuado habría de eliminar todas las bacterias presentes en este grupo y de que el envasado debería impedir la recontaminación del producto. Para resolver estos problemas, el científico, Ingram; recomendó la distinción de dos grupos de microorganismos marcadores ("marker. organisms"). En primer lugar, el grupo cuya presencia en un alimento indica la posible presencia simultánea de microorganismos patógenos ecológicamente relacionados. Tales organismos marcadores son denominados índices. Desde entonces como índice de posible presencia de microorganismos patógenos de procedencia entérica (entre ellos, Salmonella) en el agua y en los alimentos. Mucho más tarde, se introdujeron ciertos grupos de bacterias con el propósito de poner de manifiesto deficiencias en la calidad microbiología de un determinado alimento en términos más generales. Por supuesto que un determinado marcador puede funcionar como índice o indicador, incluso en un mismo alimento. Por ejemplo, la presencia de números significativos de ufc de E. coli en camarones o gambas precocidos y congelados pone de manifiesto: a) un tratamiento de inocuidad inadecuado, por lo tanto, función indicadora, b) Presencia posible de indicadores de microorganismos patógenos de procedencia entérica, función de índice para microorganismos significativos en cuanto a la salud, riesgo derivado de las industrias donde los camarones fueron procesados.
En el momento actual, es posible la determinación directa de casi todos los microorganismos patógenos entéricos. No obstante, existe todavía en la microbiología moderna analítica de los alimentos para pruebas o determinaciones adecuadamente diseñadas de microorganismos marcadores, además de buscar o aislar microorganismos patógenos. Damos algunas razones que lo justifican:
El fallo en la determinación de entorobacteriacea patógenas concretas tienen un significado alto (limitado), debido a la frecuente distribución muy irregular de estos microorganismos en los alimentos y a la falta de fiabilidad de las técnicas de aislamiento.
Por otro lado, no es posible en un laboratorio no especializado detectar la presencia en los alimentos de ciertos agentes patógenos entéricos, tales como el virus de la Hepatitis A, y los helmintos.
Además, aun cuando falten en efecto todos los agentes patógenos entéricos en una alicuota adecuada de una partida de alimentos este resultado tiene únicamente significado de lo que se refiere a partida o lote en cuestión.
La familia de las enterobacteriáceas comprende muchos géneros de los que unos se caracterizan porque fermentan la lactosa (por ej., Escherichia y Enterobacter) y otros por no hacerlo (por ej., Proteus no enteropatógeno, Serratia, Salmonella y Shigella). Se sostiene que hay una estrecha correlación entre los recuentos totales de enterobacteriáceas y el grado de contaminación fecal, sobre todo por salmonelas; debido a las muchas discrepancias encontradas cuando se utilizaron otras pruebas más convencionales para coliformes, sugirieron que sería mejor emplear el recuento total de enterobacterias.
Las discrepancias observadas con las pruebas para coliformes fueron: (1) si el producto sólo contuviera Salmonella sp., los resultados obtenidos serían falsos; (2) en ocasiones predominan las estirpes de E. coli no fermentadoras; (3) a veces las cepas no producen gas aunque ataquen a la lactosa; (4) en todo caso la definición de coliformes es demasiado inconsistente y por lo tanto está justificada la nueva prueba. La prueba, tal y como la sugieren Mossel et al. (1963), implica un enriquecimiento en BGBB de las muestras del alimento homogeneizadas (la razón de este enriquecimiento se da en la sección siguiente); el BGBB empleado en esta prueba es una modificación del empleado para confirmar los coliformes, en el sentido de sustituir la glucosa por la lactosa ya que por definición todos los miembros de las enterobacteriáceas, atacan a la glucosa con producción de gas. La incubación tiene lugar a 37º C durante 24 horas, lo que va seguido normalmente de siembras de los caldos con crecimiento (esto es, turbios) en placas de agar de MacConkey modificado o en Agar rojo violeta bilis (VRBG o VRBL); la modificación consiste en la sustitución del azúcar. Todas las colonias que muestran un color característico rojo o púrpura se consideran enterobacteriáceas. Es necesario insistir en que la presencia, incluso de un número sustancial, de microorganismos indicadores no significa con certeza que haya ocurrido la contaminación fecal de los alimentos procesados; también puede indicar un procesado inadecuado, una contaminación posterior o unas condiciones de procesado antihigiénicas, especialmente si los alimentos se han almacenado a temperaturas que permiten el crecimiento microbiano. El empleo de las enterobacterias (coliformes y no coliformes) como microorganismos indicadores se basa en que estas bacterias son destruidas por los tratamientos de pasteurización, térmicos o clorado de las aguas con gran facilidad. Por esto, la presencia de altos valores de enterobacteriaceae en los alimentos es síntoma de fallos en el proceso de elaboración o de conservación que pueden acarrear riesgos para el consumidor. Su empleo como indicadores es preferible al simple análisis de coliformes (bacterias lactosa positivas) porque la frecuencia de estos últimos puede ser menor, su determinación incierta (caso de cepas de Escherichia coli fermentadoras lentas o caso de cepas no fermentadoras en Enterobacter) y a la menor sensibilidad de las pruebas para coliformes. El desarrollo de métodos específicos para la detección de enterobacterias totales puede ser una buena estrategia en función de la relación costo/beneficio. Esta detección puede ser la única que se lleve a cabo en regiones con pocos recursos analíticos.
Siempre que sea posible hay que completar el estudio con el análisis específico de enteropatógenos y hay que valorar los riesgos de la presencia de "falsos positivos" (altos valores de enterobacteriaceae sin presencia de enteropatógenos, lo que apoya su utilización como indicadores en vez de como índices) y de "falsos negativos" ( presencia de Salmonella spp. cuando los valores de enterobacteriaceae son bajos). En la mayoría de los casos estudiados se ha comprobado que el recuento de enterobacteriaceae supone una garantía suficiente para el consumidor.; en cualquier caso, los resultados son más fiables que cuando se utilizan como indicadores sólo los recuentos de coliformes porque éstos últimos suelen ser más bajos y, por lo tanto, más sujetos a error. Los métodos generales son el uso del Agar con Cristal Violeta, Rojo Neutro, Bilis y Glucosa como medio selectivo y, como medio de enriquecimiento, Caldo tamponado con Cristal Violeta, Bilis y Glucosa. En estos medios, la Bilis supone el agente selectivo principal ayudado por el colorante Cristal Violeta; el rojo neutro es indicador de pH para detectar la fermentación. Hay que tener en cuenta la posible presencia de organismos dañados por la situación biológica del alimento (baja aw, bajo pH), por las condiciones desfavorables de almacenamiento (caso de microorganismos no esporulantes, frío, congelación) o por el tratamiento por calor. Hay que distinguir tres niveles de identificación: 1º Fase de presunción o probabilidad (detección de microorganismos que crecen en Agar-Cristal-Violeta-Rojo-Neutro-Bilis-Glucosa o microorganismos productores de gas en caldo con Verde Brillante); 2º Fase de confirmación (detección de microorganismos con respuesta positiva en medio de MacConkey); y 3º, Fase de determinación (pruebas finales de fermentación de la glucosa y prueba de la oxidasa).
AEROBIOS MESOFILOS
Son todas aquellas bacterias aerobias o anaerobias facultativas, mesófilas o psicrófilas capaces de crecer en agar nutritivo. Se investigan por el método de recuento en placa con siembra en profundidad, que se basa en contar el número de colonias desarrolladas en una placa de medio de cultivo sólido (Agar para recuento en placa o PCA), donde se ha sembrado un volumen conocido de la solución madre o sus diluciones (1 ml) , incubadas a 37° C durante 24 hs. Se deberán contar todas las colonias desarrolladas en cada placa. Si se ha sembrado más de una dilución se seleccionará la que proporcione entre 30 y 300 colonias, descartando las demás. El recuento no se efectuará en placas que contengan menos de 30 colonias, excepto en aquellas sembradas con solución sin diluir. Los recuentos "totales" expresan el número por gr o ml de (ufc), de alimentos obtenido en determinadas condiciones de cultivo en medio sólido incubado en aerobiosis. No existe una relación directa entre la flora aerobia y la posible presencia en los alimentos de microorganismos patógenos de procedencia intestinal, ni tampoco de otros agentes de infecciones e intoxicaciones alimentarias de diversas procedencia. En realidad un recuento alto de ufc en un alimento indica que, probablemente, ha estado conservado en condiciones de tiempo y temperatura que han permitido el desarrollo de microorganismos. La simplicidad de la técnica hace que el recuento de la placa en flora aerobia viable sea un paso inicial frecuente en el análisis microbiológico de los alimentos.
Es importante primero, elegir adecuadamente la temperatura de incubación. En segundo lugar, ha de utilizarse un medio de cultivo adecuado. En alimentos no obtenidos por fermentación, conviene un agar infusión que permitirá incluso el crecimiento de los microorganismos de cultivo más difícil, por ejemplo el medio de uso múltiple con tween 80 ("all purpose tween= APT) ó el agar tamponado glucosa triptona peptona de soya con extracto de levaduras. En alimentos congelados y en los conservadores en refrigeración, los recuentos de la flora bacteriana psicrotrofa pueden relacionarse con las condiciones de conservación y son indicativos de la calidad bacteriológica en estos productos. En algunos alimentos tales como, los envasados al vacío, está indicado el recuento de la flora anaerobia mesófila, no debe utilizarse el tioglicolato sódico en los medios para el recuento de anaerobios. Los resultados de este análisis permiten:
Verificar efectividad de los procedimientos de limpieza y desinfección.
Determinar si las temperaturas aplicadas en los procesos fueron las adecuadas.
Determinar el origen de la contaminación durante los procesos de elaboración de los alimentos.
Verificar condiciones óptimas de almacenamiento y transporte.
Obtener información acerca de la vida útil de los alimentos.
Indicar alteración incipiente en ciertos alimentos.
El análisis de los alimentos para determinar la existencia, tipo y número de microorganismos es básico para la microbiología de alimentos. Sin embargo ninguno de los métodos utilizados habitualmente permite determinar el número exacto de microorganismos que existe en un determinado alimento. El recuento en placa con siembra en profundidad es el método más utilizado para la determinación del número de células viables o unidades formadoras de colonias (ufc) en un alimento, pero deben hacerse en función de uno de los siguientes factores:
- método de muestreo utilizado
- distribución de los microorganismos en la muestra
- naturaleza de la microflora del alimento
- naturaleza del alimento
- antecedentes del alimento
- adecuación nutricional del medio de cultivo
- temperatura y medio de incubación
- pH, aw, potencial de oxidación reducción del medio
- tipo de diluyente utilizado
- número relativo de microorganismos en la muestra
Los recuentos de microorganismos viables se basan en el número de colonias que se desarrollan en placas previamente inoculadas con una cantidad conocida de alimento e incubadas en unas condiciones ambientales determinadas. Estos recuentos no pueden considerarse como recuentos totales ya que solo son susceptibles del contaje aquellos microorganismos capaces de crecer en las condiciones establecidas. Se puede conseguir una amplia gama de condiciones variando la temperatura, la atmósfera, la composición del medio y el tiempo de incubación. Un recuento bajo de aerobios mesófilos no implica o no asegura la ausencia de patógenos o sus toxinas, de la misma manera un recuento elevado no significa presencia de flora patógena. Ahora bien, salvo en alimentos obtenidos por fermentación, no son recomendables recuentos elevados. Un recuento elevado puede significar:
- Excesiva contaminación de la materia prima
- Deficiente manipulación durante el proceso de elaboración
- La posibilidad de que existan patógenos, pues estos son mesófilos
- La inmediata alteración del producto
Métodos normalizados ISO 4833 Directiva general para el recuento de microorganismos. Método por recuento de colonias a 30º C
Este método se basa en la siembra en profundidad en un medio de cultivo definido, vertido en dos placas de Petri, con una cantidad determinada de muestra si el producto a examinar es líquido, o con una cantidad determinada de suspensión madre en el caso de otros productos. En las mismas condiciones, siembra de las diluciones decimales obtenidas de la muestra o de la suspensión madre. Incubación a 30º C, en aerobiosis durante 72 horas. A partir del número de colonias obtenidas en las placas de Petri, calcular el número de microorganismos por mililitro o por gramo de muestra.
Este método se basa en la siembra en profundidad en un medio de cultivo definido, vertido en una placa de Petri, con una cantidad determinada de muestra si el producto a examinar es líquido, o con una cantidad determinada de suspensión madre en el caso de otros productos. En las mismas condiciones, siembra de las diluciones decimales obtenidas de la muestra o de la suspensión madre. El recuento podrá ser realizado utilizando un sembrador espiral (NF V08-100) Incubación a 30º C, en aerobiosis durante 72 horas. A partir del número de colonias obtenidas en las placas de Petri escogidas, calcular el número de microorganismos por mililitro o por gramo de muestra. Los microorganismos aerobios mesófilos son la flora total compuesta por bacterias, hongos filamentosos y levaduras, aerobios estrictos o facultativos que presentan unas características térmicas intermedias. Con este análisis se refleja la calidad sanitaria e higiénica de la elaboración del alimento. Altos recuentos no son aconsejables salvo en el caso de los productos fermentados. Tasas de 106 ó 107 gérmenes/g indican descomposición del producto. Para llevar a cabo el análisis microbiológico de los microorganismos aerobios totales, se utiliza un medio general para que puedan crecer todos los microorganismos que interesan. Existen medios generales como el PCA (Plate Count Agar), TSA (Triptosa Soja Agar) o AN (Agar Nutritivo) en los que se encuentran todos los nutrientes necesarios para que crezcan la inmensa mayoría de los microorganismos.
Otros medios son selectivos y diferenciales como el VRBG (Violeta rojo bilis glucosa) para la determinación del género Enterobacteriaceae. De esta forma, con la composición de ese medio, crece el género nombrado anteriormente pero no la gran mayoría de los demás ya que o no contiene todos los nutrientes necesarios para el resto o bien contiene algún elemento que les impide el crecimiento. Lo ideal sería que existieran medios que permitieran crecer únicamente al microorganismo cuya determinación se lleva a cabo, pero esto suele ser un ideal que no se suele alcanzar y las pruebas microbiológicas suelen ir acompañadas de confirmaciones bioquímicas para asegurar que la determinación se ha realizado sobre el microorganismo que interesa. En este caso, el análisis se realiza con PCA y se suele llevar a cabo con una dilución del orden de 10-5 aunque es variable según el tipo de alimento. En primer lugar se toman 25 g. de una muestra representativa del producto total si es que éste es sólido, y se añade 225 ml. de agua peptonada en una bolsa estéril de Stomacher, y tras someterlo a homogenización, ya tenemos lista la dilución 10-1 de la muestra. A continuación, se realiza tantas diluciones como sean necesarias tomando 1 ml. de la dilución anterior y anadiéndola a un tubo de ensayo que contenga 9 ml. de suero fisiológica y así sucesivamente. Es muy importante que antes de que se tomen las muestras para verterlas bien en otro tubo de ensayo o bien en una placa de Petri, se homogenice bien la muestra ya que los microorganismos tienden a concentrarse en la parte baja del habitáculo donde se encuentran por sedimentación. Se toman tantas pipetas estériles como diluciones sea preciso realizar. En el caso de la siembra en masa, se vierte el ml de muestra en la placa de Petri y a continuación se vierten unos 15 ml de PCA líquido que está contenido en una botella que está en baño para que se mantenga a temperatura superior a su punto de fusión. A continuación, se homogeniza moviendo la placa de Petri en el sentido de la agujas del reloj y al contrario, y en forma de cruz. Y a continuación se deja reposar hasta que se solidifique el agar por disminución de su temperatura a la del ambiente. Finalmente, se invierte la placa para que no se produzca condensación y se introduce en una estufa a 30ºC que es la temperatura óptima de crecimiento para lo que pretendemos determinar durante 72 horas. Pasado este tiempo, se saca la placa de la estufa y se hace un recuento de las colonias. Cuando se ha vertido el ml. de muestra sobre la placa de Petri, en ella están contenidos un número determinado de microorganismos que no son apreciables a la vista.
Sin embargo, una vez que se les incubado a su temperatura óptima de crecimiento, pasado el tiempo se ha dado crecimiento bacteriano por lo que a partir de cada microorganismo individual se obtiene una colonia compuesta por millones de microorganismos que sí que se pueden contar a simple vista (las colonias). Por ello, cuando se dan los resultados de la muestra, se dice UNIDAD FORMADORA DE COLONIA ya que cada microorganismo ha formado una colonia. En el caso de la siembra en superficie, primero se vierte el PCA en la placa de Petri y se deja solidificar. Una vez ha solidificado el agar se vierte 1 ml. ó 0,1 ml de muestra y se extiende con un Ansa de Drigalski por el agar hasta que éste lo absorbe y entonces es cuando la placa ya está lista para ser incubada.
ENTEROCOCOS
Como antes se ha indicado, los enterococos comprenden dos especies encontradas en los intestinos humanos y animales, concretamente Streptococcus faecalis y S. faecium. El primero se encuentra fundamentalmente en el intestino humano, mientras que el segundo se encuentra tanto en el hombre como en los animales. Los enterococos se emplean a veces como indicadores de contaminación fecal en el análisis del agua; una de las ventajas sobre E. coli es que mueren más lentamente y uno de los inconvenientes que se encuentran con más frecuencia que aquel en ambientes no fecales y por lo tanto su aislamiento no indica tan claramente contaminación fecal. Se ha señalado con frecuencia que en los alimentos los enterococos constituyen una mejor indicación del estado sanitario que E. coli; generalmente se recuperan antes que los coliformes, sobre todo en los alimentos congelados y en los deshidratados, así como en los que han sufrido un tratamiento térmico moderado. Sin embargo, esta mayor capacidad de recuperación rebaja su valor como microorganismos indicadores, ya que su presencia, por ejemplo, en los alimentos tratados por el calor, tiene poco valor si otros microorganismos patógenos menos termoestables, como las salmonelas, se han destruido durante el tratamiento térmico.
Se dispone de muchas técnicas para el aislamiento y enumeración de enterococos que generalmente se basan en el empleo de la azida de sodio como agente selectivo y a menudo en temperaturas de incubación altas (44º C). Ejemplo de medio corrientemente utilizado es el KF Streptococcus agar (Difco) que, además de los nutrientes corrientes, contiene también cloruro de tetrazol, ingrediente que da a las colonias color rojo; la incubación se realiza a 37º C durante 48 horas. Como alternativa puede utilizarse caldo de glucosa azida, incubando a 44º C y llevando a cabo el recuento con la técnica del MPN y tablas de probabilidad. Los tubos en los que se aprecia producción de ácido se consideran positivos (N.B. los enterococos no originan gas a partir de la glucosa). Generalmente no se necesita la identificación de la especie ni de la estirpe. La enumeración de bacterias o grupos de bacterias indicadoras de contaminación fecal es utilizada para valorar la calidad sanitaria de alimentos, sedimentos y aguas destinadas al consumo humano, la agricultura, la industria y la recreación. No existe un indicador universal, por lo que los especialistas deben seleccionar el apropiado para la situación específica en estudio. Dentro del rango de los indicadores se encuentra el grupo de bacterias coliformes, E. coli, colifagos, Bifidobacterium sp., Clostridium perfringens y el grupo estreptococos fecales.
Los microorganismos mencionados anteriormente se encuentran formando parte de la flora intestinal del tracto gastrointestinal del hombre y en los animales de sangre caliente; son excretados en sus heces, de ahí que su presencia en el ambiente indique contaminación de origen fecal y el riesgo de aparición de gérmenes patógenos. Los estreptococos fecales han sido utilizados por las autoridades sanitarias de diferentes países para evaluar la calidad sanitaria de sus recursos naturales. En el pasado, el principal papel de este grupo de microorganismos fue la utilización de la proporción coliforme fecal/estreptococo fecal como un indicador de la naturaleza de la fuente fecal; sin embargo, factores como: las diferencias de los rangos de muerte en el ambiente entre estos dos indicadores, la supervivencia variable de los grupos de especies de estreptococos fecales y los métodos para la determinación de estos últimos, hizo que su empleo fuera cuestionable. El término enterococos fue utilizado por primera vez en 1899 por Thiercelin para describir diplococos grampositivos de origen intestinal que formaban pares o cadenas cortas. Estos microorganismos fueron clasificados dentro del género Streptococcus como Streptococcus faecalis por Andrewes y Horder en 1906. Un segundo microorganismo fecal, Streptococcus faecium, que presentaba características similares al anterior fue descripto por Orla – Jensen en 1919. El género Streptococcus es un grupo heterogéneo de bacterias grampositivas con gran significación para la medicina y la industria, son esenciales en procesos industriales y lácteos y como indicadores de contaminación. Varias especies son importantes desde el punto de vista ecológico como parte de la flora microbiana normal del hombre y los animales, otras pueden ser causa de infecciones que varían en un rango de subagudas a agudas hasta crónica. Sherman en 1937, propuso un sistema de clasificación que separaba este género en cuatro divisiones: pyogenes, láctico, viridans y enterococo. Este esquema se correlacionó con el propuesto sobre bases serológicas por Lancefield en 1933, quien designó los grupos como A, B, C, D, etc. donde los enterococos reaccionaban con el antisuero grupo D.
Desde el establecimiento del género Enterococcus con los estudios quimiotaxonómicos y filogenéticos realizados, se han transferido y descrito nuevas especies en este género por lo que su complejidad aumenta y la diferenciación de algunas de estas especies resulta problemática debido a la coincidencia de características fenotípicas. Los enterococos son cocos grampositivos, catalasa negativa, inmóviles, anaerobios facultativos y no forman endosporas ni cápsulas. Entre las características fisiológicas que distinguen al género Enterococcus se encuentra la habilidad para crecer en presencia de 6,5 % de CLNa; a 10° C y 45° C y pH 9,6. Son capaces de hidrolizar la esculina en presencia de 40 % de bilis y poseen la enzima pyrrolidonyl arylamidasa. Desafortunadamente, no existe una característica de las mencionadas que sea única para este género; las cepas de bacterias en forma de cocos, Gram positivos y catalasa negativa de los géneros Streptococcus, Lactococcus, Aerococcus, Gemella, Leuconostoc y Lactobacillus pueden mostrar una o más de las características típicas del Enterococcus. El género Enterococcus se ha revelado como causa de infecciones nosocomiales y de una variedad de infecciones adquiridas en la comunidad, además de ser intrínsecamente resistentes a un número de agentes antimicrobianos. Entre las especies de mayor importancia clínica se destacan, Enterococcus faecalis que constituye el 85 – 90 % de los aislamientos en la mayoría de los laboratorios y Enterococcus faecium del 5 – 10 % de las cepas detectadas clínicamente.
Las especies de origen fecal o intestinal pertenecen principalmente a dos géneros: Enterococcus y Streptococcus. Se propone que sea adoptado el término enterococos y estreptococos intestinales como principal grupo indicador de riesgo para la salud pública. Existen 14 especies de los géneros Enterococcus y Streptococcus que se consideran de origen fecal o intestinal. En un ensayo comparativo realizado a gran escala en 1995 se redujo a cuatro especies: Enterococcus faecium, Enterococcus faecalis, Enterococcus durans y Enterococcus hirae en un intento para reducir la variabilidad. A causa de los cambios en la taxonomía de Streptococcus y Enterococcus hay una pérdida de información sobre el recobrado de las diferentes especies de enterococos y estreptococos intestinales en los medios de cultivos ampliamente utilizados para el monitoreo de rutina. Los métodos para la enumeración de estreptococos fecales en muestras de aguas fueron desarrollados antes de estos cambios, por lo que es necesario evaluar el valor de cada una de las especies como indicador de contaminación fecal y estudiar cómo estos microorganismos crecen en los medios usados comúnmente en el análisis higiénico de las aguas. Por lo general, los procedimientos empleados en aguas consisten en el enriquecimiento en medio líquido de acuerdo con el método del número más probable y la técnica de filtración por membrana. En el primero se ha determinado que los medios que contienen azida de sodio producen los mejores resultados; en cuanto al segundo, más de 70 medios han sido propuestos para la determinación de estreptococos fecales por dicha técnica.
No ha sido posible obtener un medio completamente selectivo para todos los estreptococos y enterococos. Los medios selectivos usualmente están constituidos por un agente como la azida de sodio, un antibiótico (con frecuencia gentamicina o kanamicina) o sales biliares y un indicador que puede ser esculina o tetrazolium. La incubación a temperaturas elevadas (44° C) tiene también un efecto selectivo para algunos enterococos. La composición de los medios selectivos más comunes no es la más adecuada para el recobrado de Streptococcus sp. Hay diversidad de opiniones en cuanto al valor de los estreptococos fecales como indicador de contaminación fecal. En investigaciones realizadas en países tropicales se plantea que estas bacterias pueden estar presentes de forma natural en las corrientes y no reflejan necesariamente el grado de contaminación de dichas aguas por lo que se considera la hipótesis de que la fuente de la alta concentración de bacterias indicadoras en las corrientes es el suelo. Por otra parte, los riesgos asociados con las actividades en aguas naturales destinadas a la recreación en los que se incluyen enfermedades del tracto respiratorio superior y enfermedades gastrointestinales, infecciones del oído e infecciones de la piel han ocasionado que algunos investigadores de Canadá recomienden como el indicador más apropiado en aguas marinas el grupo enterococo, porque sobreviven en ellas más que los coliformes fecales, también son elegidos cuando hay un tiempo o distancia considerable entre la fuente de contaminación fecal y el área de baño. Además, existe una correlación positiva entre la enfermedad gastrointestinal y los niveles de enterococos en aguas marinas, aunque la ausencia de ellos no indique carencia de riesgo. La Organización Mundial de la Salud (OMS) plantea que el valor principal de los estreptococos fecales en el examen de la calidad del agua potable es como indicadores adicionales de la eficiencia del tratamiento, además de ser valiosos para los controles corrientes después del tendido de nuevas cañerías maestras o cuando se reparan los sistemas de distribución, para detectar contaminación de las aguas subterráneas o de superficie por las escorrentías.
La relativa resistencia de los enterococos a condiciones adversas como la tolerancia a condiciones extremas de temperaturas, pH y salinidad, es ventajosa cuando se determina la historia sanitaria de alimentos moderadamente calentados, congelados, salados u otro alimento o bebida en los cuales los coliformes pueden no haber sobrevivido. Sin embargo, a causa de la habilidad de los enterococos para crecer en ambientes lejanos de la fuente original de contaminación fecal se recomienda precaución y discreción en atribuirle una significación al número y tipo de enterococos y estreptococos fecales presentes en los alimentos. La presencia de algunas especies en el género Enterococcus que al parecer no tienen relación con la materia fecal, disminuye el interés por los enterococos como indicadores de la inocuidad de los alimentos, por lo que se revisa su utilidad en el control de la higiene y la calidad de los alimentos. En estudios futuros resulta necesario determinar si las especies de enterococos y estreptococos intestinales reportadas en los últimos años se encuentran solamente asociados con contaminación fecal o se presentan en forma natural, con el objetivo de valorar la importancia de este grupo de bacterias como indicador para evaluar la calidad sanitaria de muestras ambientales en países tropicales.
"SOMOS LO QUE HACEMOS REPETIDAMENTE. EXCELENCIA, POR LO TANTO, NO ES UN ACTO SINO UN HÁBITO"
ARISTOTELES
LEGALES: El autor no asume responsabilidad alguna por la descarga, copia, distribución, modificación o alteración de los contenidos publicados, sean propios del mismo o de terceros, los cuales pudieren estar protegidos por Copyright, Derechos de Propiedad Intelectual, Derechos de Autor, o relacionados. La Bibliografía del tema expuesto y el crédito fotográfico está en poder del Autor y no se publica dada su extensión, pero se enviará por mail al interesado que la solicitare debidamente fundamentada.